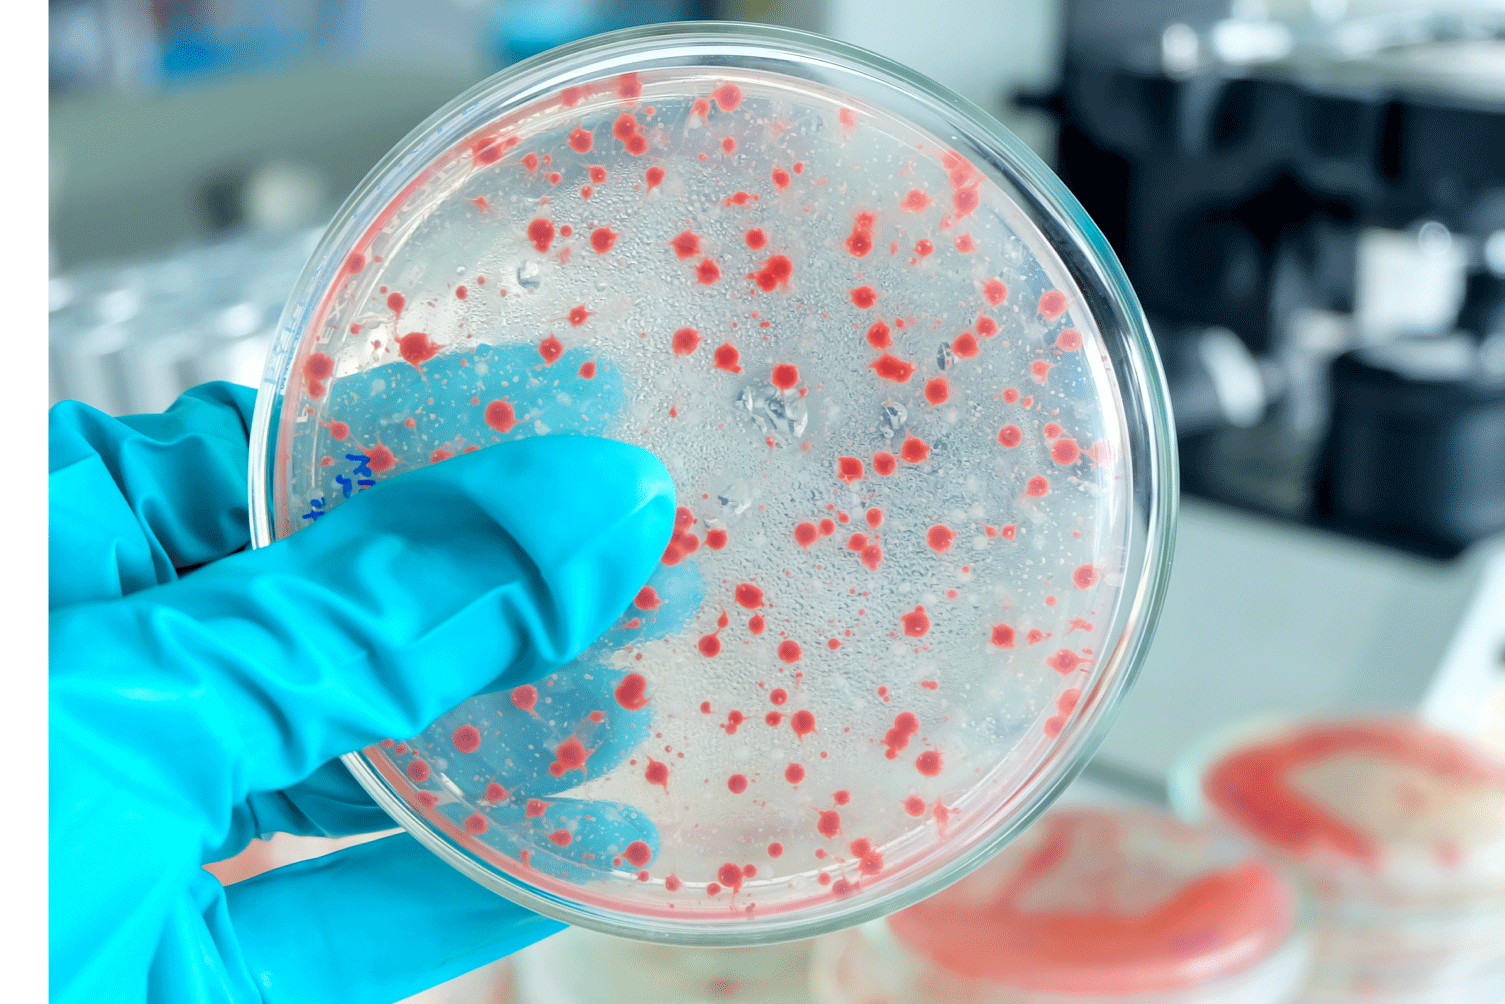

Eau, air, surfaces, solides, boues, jouets ou matrices complexes : des solutions analytiques fiables en microbiologie environnementale pour répondre aux exigences sanitaires et réglementaires.

Garantissez la conformité sanitaire grâce à nos analyses parasitaires spécialisées et réglementaires

Découvrez nos analyses virologiques spécialisées pour identifier les virus sur toutes vos matrices.

Accompagnement complet pour vos études microbiologiques, de la R&D à la validation

Analyses ciblées et adaptées pour germes spécifiques et des matrices complexes

Vous avez besoin d'un agrément sanitaire pour votre unité de méthanisation ou votre centre de compostage ?
Envie d'en savoir plus ?